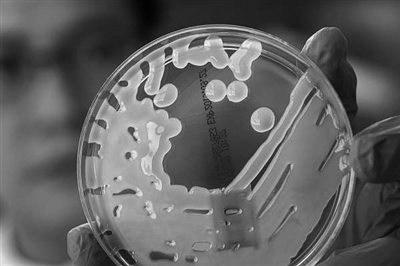

|
| 培养皿上的耐药肺炎克雷伯菌 (视觉中国供图) |
一项最新研究表明,伤寒杆菌对常用于治疗伤寒的抗生素药物,如大环内酯类和喹诺酮类的耐药性越来越强,且在过去的30年中,耐药性菌株得到了广泛传播。这项研究6月22日在《柳叶刀·微生物》上发表。
伤寒是一个全球公共卫生问题,每年造成1100万例感染和10多万人死亡。抗生素虽可成功治疗伤寒感染,但其有效性近年来也受到耐药性菌株的威胁。截至目前,对耐药性伤寒杆菌的上升和扩散的分析有限,且大多数研究基于小样本。
《柳叶刀》这项新研究使用遗传数据库鉴定了来自70多个国家的7658个伤寒杆菌菌株中的抗性赋予基因。测序分析显示,在过去30年中,伤寒杆菌耐药菌株在世界各国之间已传播了至少197次。
事实上,近年来细菌等微生物对抗生素的耐药性问题一直困扰着全球医学界。今年1月,《柳叶刀》就曾发表过一项迄今为止对微生物耐药性全球影响最全面的一项分析。通过对204个国家和地区的数据分析显示,微生物耐药已成全球死亡的主要原因,其致死人数已超过艾滋病感染或疟疾造成的死亡。研究估计,2019年,微生物耐药性感染直接导致了127万人死亡,间接导致了495万人死亡。
随着英国细菌学家亚历山大·弗莱明在1928年发现青霉素,人类有了抵抗多种感染性疾病的强大武器。然而,近年来,超级细菌的出现却让临床陷入了无药可用的尴尬境地。既往研究预测,到2050年,全球将每年约有1000万人死于抗菌药物耐药。但业界认为,这一时间节点可能会提前到来。
全国细菌耐药监测网监测结果显示,目前我国已出现细菌耐药现象,如造成社区获得性肺炎的肺炎链球菌对红霉素、阿奇霉素等常规抗菌药物的耐药率高达95%以上,造成尿路感染最常见的大肠埃希菌对左氧氟沙星等常用抗菌药物的耐药率达到50%以上,造成儿童社区获得性肺炎的常见病原体——肺炎支原体对常用治疗药物的耐药率接近90%。
不仅我国面临这样的问题,全球也都面临着同样的难题。比如,万古霉素曾经作为治疗革兰阳性菌感染的最后一道防线,但在欧洲一些国家,屎肠球菌对万古霉素的耐药率达到了40%。这是因为欧洲曾经使用万古霉素的同类药物阿伏帕星作为饲料添加剂,此后在家禽、家畜的粪便中检出大量万古霉素耐药肠球菌,并通过各种途径传给了人。因此欧洲很多国家曾在健康人的肠道中分离出较高比例的万古霉素耐药肠球菌。而美国也由于在临床上长期、大量应用万古霉素,导致屎肠球菌对其耐药率高达80%以上。
面对如此严峻的耐药形势,人类该如何应对?《柳叶刀·微生物》该项研究的主要作者、美国斯坦福大学教授杰森·安德鲁森认为,迫切需要采取更大规模的行动,包括优化现有抗生素的使用、采取更有力的行动来监测和控制感染,并提供更多资金来研发新的抗生素和治疗方法。
而北京大学临床药理研究所副所长、北京大学第一医院抗感染科主任医师郑波教授则认为,虽然微生物耐药是临床医生不愿意见到的事情,但这其实是一种自然现象,它是微生物逐渐进化出来的、保护自己不被自然界本身就存在的抗微生物物质杀死的本领。耐药基因在微生物间不断传递,最终出现耐药微生物感染人类,人类不断研发新的抗微生物药物,而新的抗微生物药物很快又出现耐药这样一个恶性循环。
他认为,遏制微生物耐药需要全社会的共同行动,但公众对微生物耐药危害的认知是最重要的,只有在医生的指导下,合理使用抗菌药物这把“双刃剑”,才能在有效治疗细菌感染的同时,减少耐药细菌的发生。

 下一版
下一版




